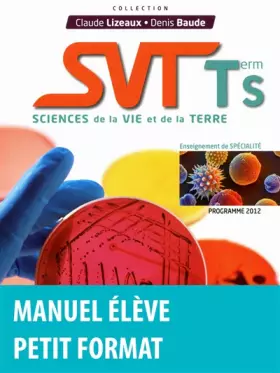
Couverture du produit · SVT term S : Sciences de la vie et de la terre (Programme 2012)

Révisions
119
résultats
Vous devez être majeur pour voir la couverture des produits pour adultes.
Vous n'avez pas trouvé l'article que vous cherchiez ?
Activez les notifications dans votre compte pour être alerté dès qu'il est en stock.